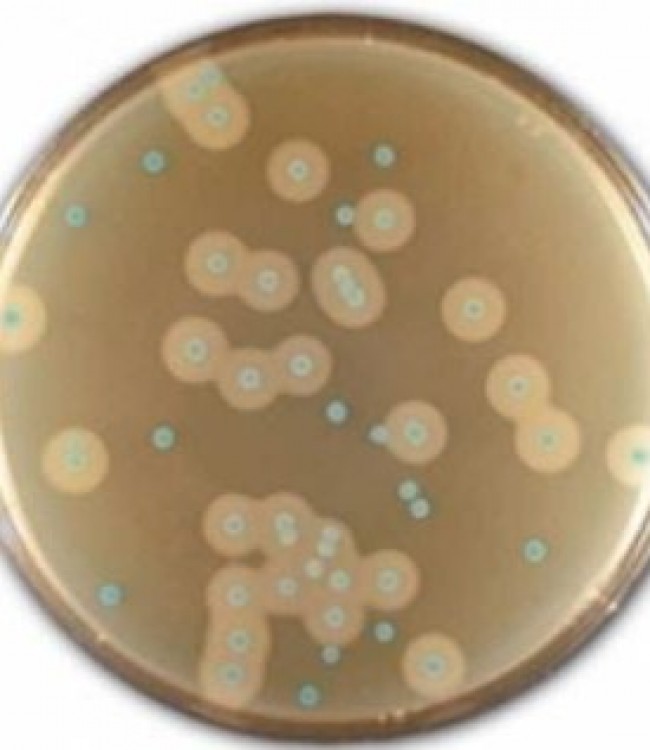
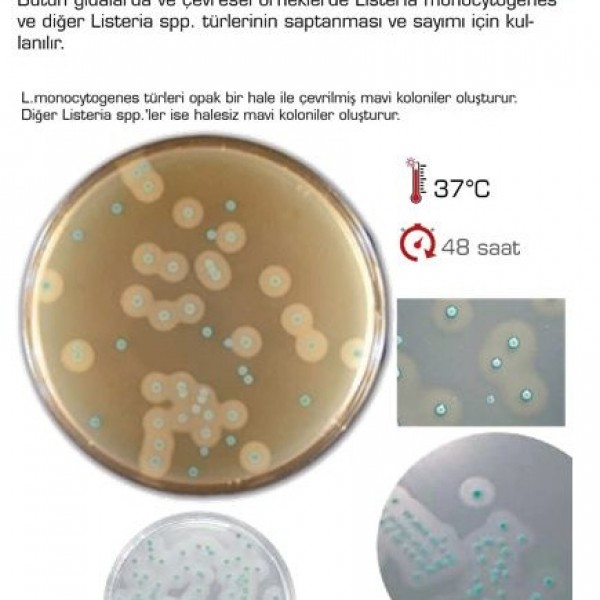
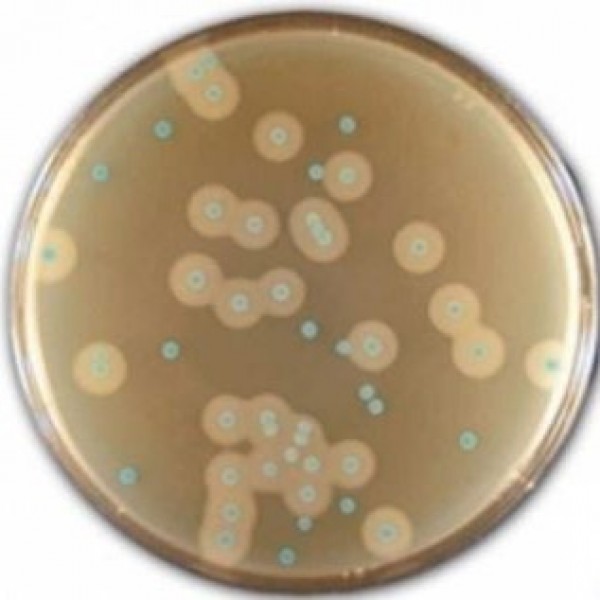

- HOME
- OUR SERVICES
- Laboratory Equipment and Chemicals
- Hazır Besiyerleri
- Chromogenic Listeria Agar
Chromogenic Listeria Agar
Chromogenic Listeria Agar
Chromogenic Listeria Agar
In whole foods and environmental samples, Listeria monocytogenes and other Listeria spp. used for the identification and enumeration of species.
is given.
L. monocytogenes species form blue colonies surrounded by an opaque halo.
Other Listeria spp. produce blue colonies without halos.
Our Services
- Detection Kits
- Laboratory Equipment and Chemicals
- Şişe Üstü Dispenserler
- Rotary Evaparator
- Çalkalayıcılar
- Kuru Blok Isıtıcı
- Vorteksler
- Viskozimetreler
- Teraziler
- Nem Tayin Cihazları
- Ph-İletkenlik-Çözünmüş Oksijen
- Elektrodlar
- Titratörler
- Refraktometreler
- NIR Analiz Cihazları-(Near Infrared)
- SpectraAlyzer FOOD/Gıda analizleri için
- SpectraAlyzer FLOUR/Un analizleri için
- SpectraAlyzer DAIRY/Süt ürünleri analizleri için
- SpectraAlyzer WINE&SPIRITS/Şarap ve alkollü içki analizleri için
- SpectraAlyzer BRAUMEISTER/Bira analizleri için
- SpectraAlyzer OLIVE/Zeytinyağı analizleri için
- SpectraAlyzer GRAIN/Tahıl analizleri için
- SpectraAlyzer TOPWINDOW
- Santrifüjler
- OHAUS FC5816R Santrifüj
- OHAUS FC5816 Santrifüj
- OHAUS FC5718R Santrifüj
- OHAUS FC5306 Santrifüj
- OHAUS FC5718 Santrifüj
- OHAUS FC5707 Santrifüj
- OHAUS FC5706 Santrifüj
- OHAUS FC5515R Santrifüj
- OHAUS FC5515 Santrifüj
- OHAUS FC5513 Santrifüj
- OHAUS FC5714 Santrifüj
- Mikro Santrifüj, Model M1324R
- Mikro Santrifüj | Stuart SCF3
- Mikro Santrifüj | Stuart SCF4
- Neya 8
- Neya 10 ve Neya 10R
- Neya 12 ve Neya 16R
- D1008
- D2012 plus
- D3024
- D1524R
- DM0424
- DM0408
- DM0408
- DM0506
- DM0412
- DM0636
- M 2815 PR REFRIGERATED CENTRIFUGE
- M 2815 P ( FULL SWING-OUT )
- M 19 HAEMATOCRIT CENTRIFUGE
- M 415 P / M 615 P / M 815 / M 4812 P
- M 4815 PR REFRIGERATED CENTRIFUGE
- Erime Noktası Tayin Cihazları
- Stuart SMP50 | Otomatik Erime Noktası Tayin Cihazı
- Stuart SMP30 | Dijital Gelişmiş Erime Noktası Tayin Cihazı
- Stuart SMP10 ve SMP20 | Dijital Erime Noktası Tayin Cihazı
- Stuart SMP11 | Analog Erime Noktası Tayin Cihaz
- Electrothermal IA9000 Serisi | Erime Noktası Tayin Cihazı
- Electrothermal Mel-Temp 1101D
- Karıştırıcılar
- Isıtıcılı Tablalar
- Data Logger
- Ebro SL 3100 Validasyon Seti
- Ebro EBI 10-T100
- Ebro EBI 25-TH
- Ebro EBI 10-TH100
- Ebro EBI 11-TP110
- Ebro EBI 100-T100
- Ebro EBI 40-TC
- Ebro EBI 20-T1
- Ebro EBI 100-T46x
- Ebro SL 3000 Validasyon Seti
- Ebro SL 1520 EBI 16 Bowie and Dick Test Set
- Ebro EBI 25-TX
- Ebro EBI 10-T24x
- Ebro EBI 25-TE
- Ebro EBI 25-T
- Ebro EBI 10-TP200
- Ebro EBI 10-TP451 / 453
- Ebro EBI 10-TP111
- Ebro EBI 10-TP231
- Ebro EBI 10-TP460
- Ebro EBI 10-TP450 / 452
- Ebro EBI 10-TP421
- Ebro EBI 10-TP322
- Ebro EBI 10-TP321
- Ebro EBI 10-TP221
- Ebro EBI 10-TP230
- Ebro EBI 10-T690
- Ozmometreler
- Homojenizatörler
- Koloni Sayıcılar
- Desikatör Kabinleri
- SICCO Star-Desikatör
- SICCO Super-Star-Desikatör
- SICCO Big-Star-Desikatör
- SICCO Maxi 1-Desikatör
- SICCO Star-Vitrum-Desikatör
- SICCO Maxi 2-Vitrum-Desikatör
- SICCO Vacuum 1-Desikatör
- 103-70 Desikatör Kabinleri
- 103-73 Desikatör Kabinleri
- 303-75 Desikatör Kabinleri
- 303-77 Desikatör Kabinleri
- 303-78A Desikatör Kabinleri
- Gıda Kontrol Cihazı
- Spektrofotometreler
- Sonikatörler
- Tüp Çeviriciler
- Elektrikli Bunzen Beki
- Döner Buharlaştırıcılar
- HPLC Kolonları ve Sarfları
- Mantolu Isıtıcılar
- Mikropipetler ve Pipet Uçları
- Şırınga Ucu ve Membrane Filtreler
- Hazır Besiyerleri
- Kromojenik E.Coli / Koliform Agar
- Baird Parker Agar - Staphylococcus Aureus
- Plate Count Agar - Toplam Bakteri Sayımı
- TBX Kromojenik Agar - E. Coli
- VRB Agar (Violet Red Bile Agar)
- VRBG Agar (Enterobacteriaceae)
- DRBC Agar (Küf - Maya Sayımı)
- Kromojenik Salmonella Agar - Salmonella SPP Tespiti
- Kromojenik E.Coli / 0157:H7 Agar
- TSC Agar (Clostridium Perfringens)
- MYP Agar (Bacillus Cereus)
- KF Streptococcal Agar
- Pseudomonas Selective Agar, Base (Cetrimide Agar)
- Listeria Monocytogenes Tespiti
- Sabouraud Dextrose Agar
- Endo Agar
- MacConkey Agar
- Malt Extract Agar
- R2 Agar
- TSA Agar
- EMB Agar
- PDA (Potato Dextrose Agar)
- TBX Chromogenic Agar
- Chromogenic E. Coli / Koliform Agar
- Chromogenic Listeria Agar
- Chromogenic Candida Agar
- Half Fraser Broth ve Fraser Broth
- Bufferred Peptone Water
- Tryptic Soy Agar
- Water Purification Systems - Saf Su Sistemleri
- Özel Soğutucu Dolaplar
- GEA - Valves and Pumps / Vanalar ve Pompalar
- Özel Soğutucu Gıda ve İçeçek Dolapları
- Hava Sterilazyon Cihazları
- Endüstriyel Filtre Grupları
- Monofilament Filtre Torbaları
- PP Polipropilen Sıvı Filtre Torbası
- PTFE (Teflon) Filtre Torbası
- PP Polipropilen Filtre Torbası
- Polyimide P84 Filtre Torbası
- Akrilik Homopolimer Filtre Torbası
- Tavan Filtre
- Cam Elyaf Filtre Torbası
- Meta-Aramid Nomex Filtre Torbası
- Antistatik Filtre Torbası
- Polyester İğneli Keçe Filtre Torbası
- Havalı Oluk Bant Bezi
- Medikal Ürünler
- Molecular Genetic Devices and Consumables
- PRP and CGF Kits
- CRO and Sponsor Pharmaceutical Companies
- Microbiology Kits and Consumables
- Blood Collection Systems
- Sterilization Control Products